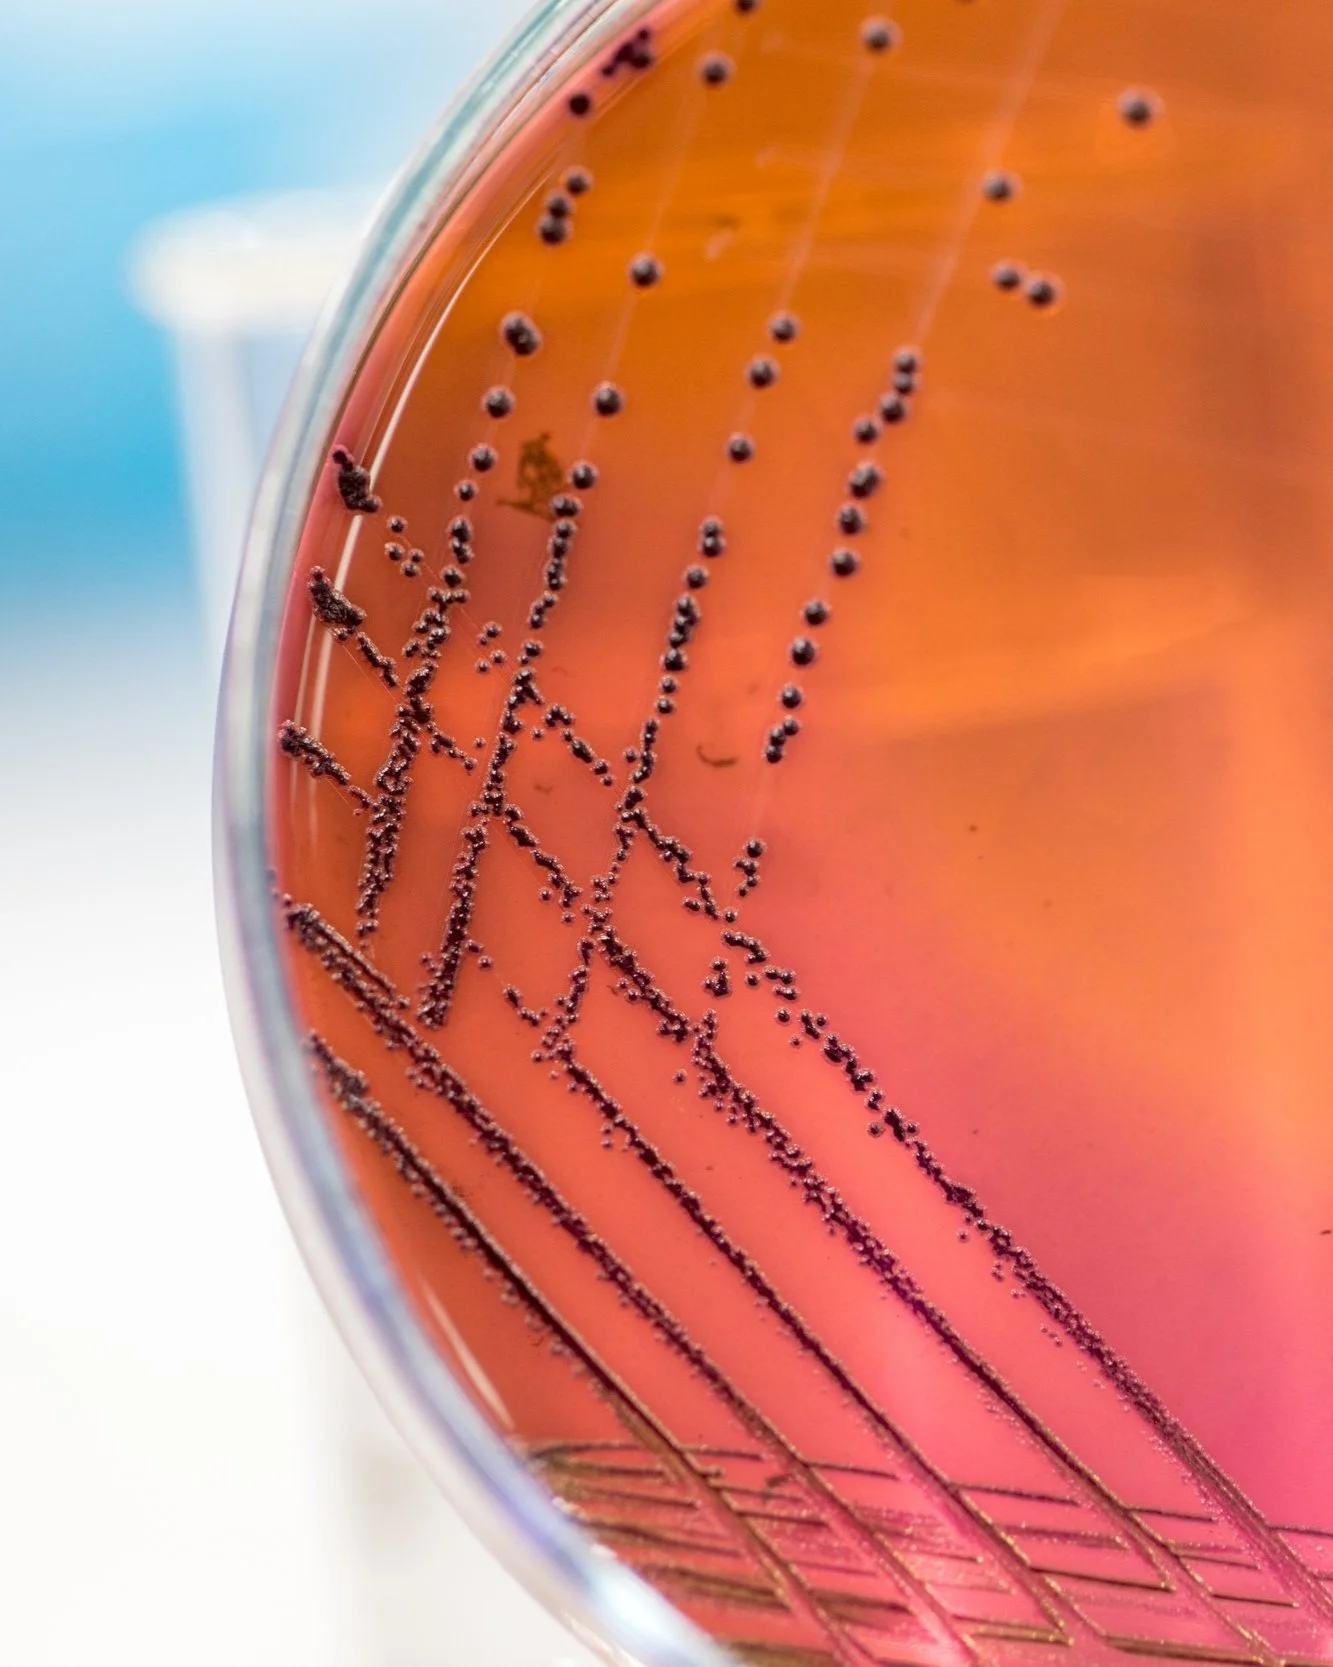

EFFLUENT TREATMENT VALIDATION
Protecting public health and the environment requires reliable effluent treatment systems that effectively reduce harmful microorganisms before discharge. Ensuring these systems perform as intended is essential, particularly when addressing viral contamination where traditional bacterial indicators may fall short. RPC is here to help!
Validating Effluent Treatment for Safer Communities and Ecosystems
Effluent disinfection and treatment systems are designed to minimize the risk of environmental contamination by reducing bacteria, viruses, and other harmful microorganisms. To confirm their effectiveness, accurate measurement and validation of system performance is critical, especially after installation or significant design or process changes. This is especially relevant for viruses since traditional bacteriological indicators of disinfection efficacy may not be representative of viral disinfection.
RPC supports municipalities, processing plants, and research facilities in evaluating and verifying the viral disinfection performance of their treatment systems. Our expertise helps ensure compliance with regulatory requirements and provides confidence in protecting communities and ecosystems.
SERVICES:
On-site inspections
Process review and consultation
Customized challenge test design
Provision of coliphage surrogate test material
Microbiological sample analysis
Detailed reports